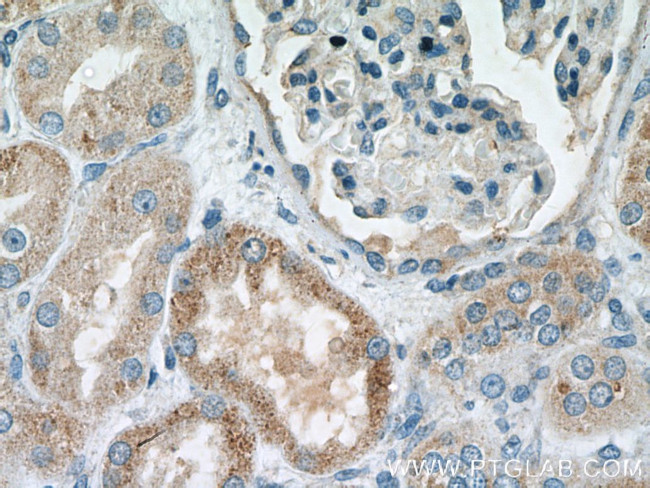
MSRB2 Antibody in Immunohistochemistry (Paraffin) (IHC (P))
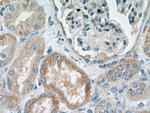
MSRB2 Antibody in Immunohistochemistry (Paraffin) (IHC (P))

Search
Proteintech
MSRB2 Polyclonal Antibody
{{$productOrderCtrl.translations['antibody.pdp.commerceCard.promotion.promotions']}}
{{$productOrderCtrl.translations['antibody.pdp.commerceCard.promotion.viewpromo']}}
{{$productOrderCtrl.translations['antibody.pdp.commerceCard.promotion.promocode']}}: {{promo.promoCode}} {{promo.promoTitle}} {{promo.promoDescription}}. {{$productOrderCtrl.translations['antibody.pdp.commerceCard.promotion.learnmore']}}
产品信息
17629-1-AP
种属反应
已发表种属
宿主/亚型
分类
类型
抗原
偶联物
形式
浓度
规格
纯化类型
保存液
内含物
保存条件
运输条件
产品详细信息
Immunogen sequence: MARLLWLLR GLTLGTAPRR AVRGQAGGGG PGTGPGLGEA GSLATCELPL AKSEWQKKLT PEQLYVTREK GTEPPFSGIY LNNKEAGMYH CVCCDSPLFS SEKKYCSGTG WPSFSEAHGT SGSDESHTGI LRRLDTSLGS ARTEVVCKQC EAHLGHVFPD GPGPNGQRFC INSVALKFKP RKH (1-182 aa encoded by BC018030)
靶标信息
MSRB2 catalyzes the reduction of free and protein-bound methionine sulfoxide to methionine.
仅用于科研。不用于诊断过程。未经明确授权不得转售。
生物信息学
蛋白别名: Methionine-R-sulfoxide reductase B2, mitochondrial; MsrB2; pilin-like transcription factor
基因别名: 2310050L06Rik; CBS-1; CBS1; CGI-131; Mrsb; MSRB; MSRB2; PILB
UniProt ID: (Human) Q9Y3D2, (Rat) Q4FZX5, (Mouse) Q78J03
Entrez Gene ID: (Human) 22921, (Rat) 361286, (Mouse) 76467